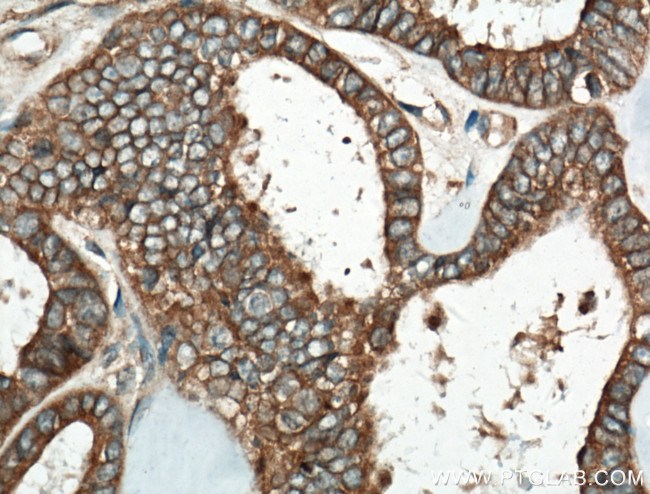
HPS6 Antibody in Immunohistochemistry (Paraffin) (IHC (P))
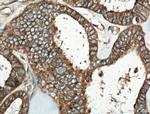
HPS6 Antibody in Immunohistochemistry (Paraffin) (IHC (P))

Search
Proteintech
HPS6 Polyclonal Antibody
{{$productOrderCtrl.translations['antibody.pdp.commerceCard.promotion.promotions']}}
{{$productOrderCtrl.translations['antibody.pdp.commerceCard.promotion.viewpromo']}}
{{$productOrderCtrl.translations['antibody.pdp.commerceCard.promotion.promocode']}}: {{promo.promoCode}} {{promo.promoTitle}} {{promo.promoDescription}}. {{$productOrderCtrl.translations['antibody.pdp.commerceCard.promotion.learnmore']}}
产品信息
11371-1-AP
种属反应
已发表种属
宿主/亚型
分类
类型
抗原
偶联物
形式
浓度
规格
纯化类型
保存液
内含物
保存条件
运输条件
产品详细信息
Immunogen sequence: DDEEAGWTE LAEQEVARLL RTELIGDQLA QLNTVFQALP TAAWGATLRA LQLQLDGNGK LRSQAPPDVW KKVLGGITAG KEPPNGILPP FELLCQCLCQ LEPRWLPPFV ELAQQQGGPG WGAGGPGLPL YRRALAVLGE EGTRPEALEL ELLLSSGRPK AVLQAVGQLV QKEQWDRALD AGLALGPSSP LLRSEIFKLL LAEFAQHRRL DAHLPLLCRL CPPELAPAEL LLLLRTYLPD EVGPPTPFPE PGAEPPLTVG LLKALLEQTG AQGWLSGPVL SPYEDILWDP STPPPTPPRD L (476-775 aa encoded by BC011594)
靶标信息
This intronless gene encodes a protein that may play a role in organelle biogenesis associated with melanosomes, platelet dense granules, and lysosomes. This protein interacts with Hermansky-Pudlak syndrome 5 protein. Mutations in this gene are associated with Hermansky-Pudlak syndrome type 6.
仅用于科研。不用于诊断过程。未经明确授权不得转售。
生物信息学
蛋白别名: BLOC-2 complex member HPS6; FLJ22501; Hermansky-Pudlak syndrome 6 protein; Hermansky-Pudlak syndrome 6 protein homolog; Hermansky-Pudlak syndrome-6 protein (HPS6); HPS6; MGC20522; RP11-302K17.1; Ru; ruby eye; Ruby-eye protein; Ruby-eye protein homolog; Ruby-eye-like protein; unnamed protein product
基因别名: 5330434M19Rik; BLOC2; BLOC2S3; HPS6; Hsp6; Ru
UniProt ID: (Human) Q86YV9, (Mouse) Q8BLY7, (Rat) Q7M733
Entrez Gene ID: (Human) 79803, (Mouse) 20170, (Rat) 309446